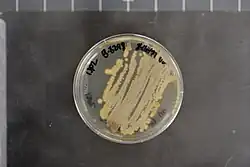

Lentzea aerocolonigenes
| Lentzea aerocolonigenes | |
|---|---|
| |
| Scientific classification | |
| Domain: | Bacteria |
| Kingdom: | Bacillati |
| Phylum: | Actinomycetota |
| Class: | Actinomycetes |
| Order: | Pseudonocardiales |
| Family: | Pseudonocardiaceae |
| Genus: | Lentzea |
| Species: | L. aerocolonigenes
|
| Binomial name | |
| Lentzea aerocolonigenes (Labeda 1986) Nouioui et al. 2018
| |
| Type strain[1] | |
| 4614 701 AS 4.1712 ATCC 23870 BCRC 13661 CBS 60 CBS 609.68 CCM 2777 CCRC 13661 CGMCC 4.1712 CIP 107109 DSM 40034 IFO 1319 IFO 13195 IFO 3837 IMET 7515 IMSNU 21350 ISP 5034 JCM 4150 JCM 4614 KCC S-0150 KCC S-0614 KCTC 9379 MTCC 1533 MTCC 1553 NBRC 13195 NBRC 3837 NCIMB 12944 NRRL B-3298 NRRL ISP-5034 R. Shinobu 701 RIA 1108 Shinobu OEU 701 VKM Ac-1081 | |
| Synonyms[1][2] | |
| |
Lentzea aerocolonigenes is a bacterium from the genus Lentzea which has been isolated from soil in Japan.[1][3][2][4] Lentzea aerocolonigenes produces rebeccamycin.[5][6]
References
- ^ a b c Parte, A.C. "Lechevalieria". LPSN.
- ^ a b "Details: DSM-40034". www.dsmz.de.
- ^ Parker, Charles Thomas; Osier, Nicole Danielle; Garrity, George M (2009). Parker, Charles Thomas; Garrity, George M (eds.). "Nomenclature Abstract for Lechevalieria aerocolonigenes (Labeda 1986) Labeda et al. 2001". The NamesforLife Abstracts. doi:10.1601/nm.6788.
- ^ George M., Garrity (2012). Bergey's manual of systematic bacteriology (2nd ed.). New York: Springer Science + Business Media. ISBN 978-0-387-68233-4.
- ^ Knölker, edited by Hans-Joachim (2012). The alkaloids (1st ed.). San Diego: Elsevier/Academic Press. ISBN 978-0-123-98282-7.
{{cite book}}:|first1=has generic name (help) - ^ Liu, editors-in-chief, Lewis Mander, Hung-Wen (2010). Comprehensive natural products II chemistry and biology (1st ed.). Oxford: Elsevier Science. ISBN 978-0-080-45382-8.
{{cite book}}:|first1=has generic name (help)CS1 maint: multiple names: authors list (link)